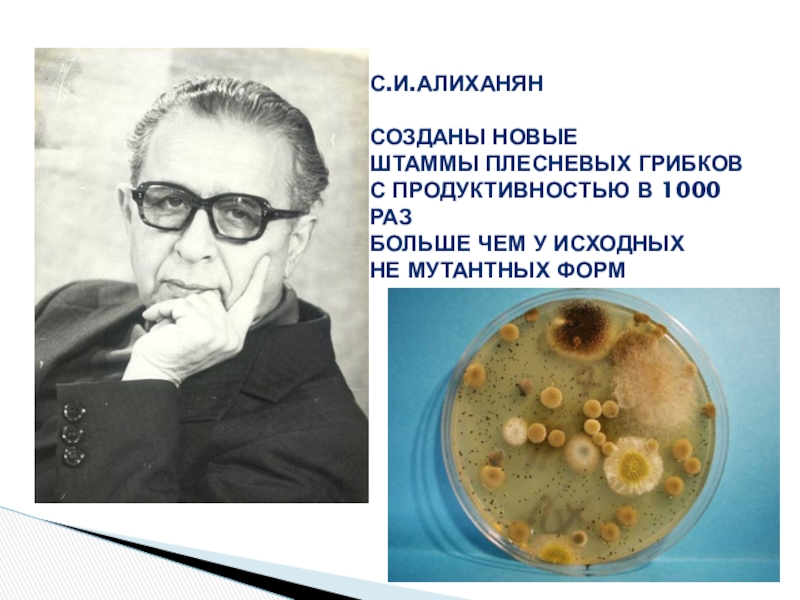

«СООШ № 5»
г. Свердловска
- Главная
- Разное
- Образование
- Спорт
- Естествознание
- Природоведение
- Религиоведение
- Французский язык
- Черчение
- Английский язык
- Астрономия
- Алгебра
- Биология
- География
- Геометрия
- Детские презентации
- Информатика
- История
- Литература
- Математика
- Музыка
- МХК
- Немецкий язык
- ОБЖ
- Обществознание
- Окружающий мир
- Педагогика
- Русский язык
- Технология
- Физика
- Философия
- Химия
- Шаблоны, фоны, картинки для презентаций
- Экология
- Экономика
Презентация, доклад по биологии на тему Экспериментальный мутагенез. Полиплоидия (10 класс)
Содержание
- 1. Презентация по биологии на тему Экспериментальный мутагенез. Полиплоидия (10 класс)
- 2. Слайд 2
- 3. Слайд 3
- 4. Г. Меллер – мутации у дрозофилы с помощью рентгеновских лучей
- 5. Слайд 5
- 6. Слайд 6
- 7. Пример химического мутагенеза – Подсолнечник «Первенец»
- 8. С.И.Алиханян созданы новые Штаммы плесневых грибков с
- 9. Слайд 9
- 10. Слайд 10
- 11. Слайд 11
Г. Меллер – мутации у дрозофилы с помощью рентгеновских лучей